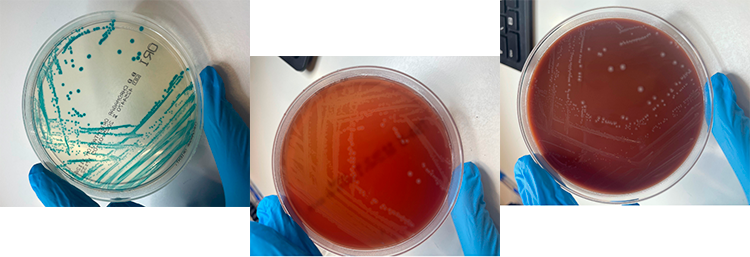

חיידק Streptococcus הוא סוג של חיידק המורכב מכמה עשרות מינים שונים.
המילה "סטרפטוקוקוס" (Streptococcus) מקורה בשפה היוונית, "סטרפטוס" (στρεπτός) פירושו "מעוגל" או "שרשרת".
"קוקוס" (κόκκος) פירושו "גרגיר" או "כדור".
המונח מתאר את הצורה האופיינית של החיידקים הללו, שהם כדוריים ונוטים להסתדר בשרשראות כאשר מסתכלים עליהם במיקרוסקופ.
סטרפטוקוקים נפוצים מאוד בסביבה הטבעית ובגוף האדם, ונמצאים במערכת הנשימה העליונה, בפה, במעיים ובאזורי עור שונים.
אחד המאפיינים המעניינים של סטרפטוקוקים הוא הסתגלותם לסביבות שונות.
הם מסוגלים לחיות בתנאים עם חמצן (אירוביים) וגם בתנאים חסרי חמצן (אנאירוביים) מה שמעניק להם יתרון הישרדותי.
סטרפטוקוקוס מקבוצה B (Group B Streptococcus – GBS) המוכר גם בשם:
Strep. agalactiae ידוע בשל נטייתו להדביק בני אדם ובמיוחד לאכלס את הרירית הווגינאלית והרקטלית.
כ־20% מהנשים ההרות הן נשאיות של GBS כלומר החיידק נמצא בנרתיק או ברקטום שלהן ללא תסמינים או בעיות כלשהן. נשאוּת ל־GBS היא לא דבר קבוע, והחיידק יכול להופיע ולהיעלם בלי שום תסמינים ובלי שנהיה מודעים לכך שהוא קיים בגוף שלנו.
עם זאת, בקרב נשים בהיריון, GBS עלול לגרום לסיבוכים ולמחלות קשות אצל הילוד, ואף לתמותה שלו.
אישה הנושאת GBS עלולה להעביר את החיידק לתינוק שלה בעת הלידה. במקרה והתינוק נדבק בGBS הוא עלול לסבול באחד משני סוגים של זיהום:
• זיהום מוקדם – מתרחש בד"כ אחרי 24-48 שעות מהלידה ועלול לגרום לזיהום בריאות, זיהוםבדם ולדלקת קרום המוח.
• זיהום מאוחר – מתרחש בד"כ לאחר 6 ימים מהלידה ועלול גם הוא לגרום לדלקת קרום המוח, דלקת ריאותומחלות אחרות.
חשוב לציין ששני שלבי הזיהומים מסוכנים לתינוק ועלולים לגרום לסיבוכים משמעותיים.
ההבדל בין GBS לסטרפטוקוקים אחרים (כמו סטרפטוקוקוס A) טמון בסוג האנזימים והחלבונים שמופרשים על ידי החיידק. סטרפטוקוקוס A, למשל, אחראי למחלות כמו דלקת גרון או "החום הסטפטי", בעוד ש-GBS לרוב גורם לדלקת בדרכי השתן, דלקת ריאות, או אצל תינוקות – מיני זיהומים כמו אלח דם – מצב מסכן חיים שנגרם בעקבות תגובת יתר של מערכת החיסון של הגוף לזיהום (נוכחות של מיקרואורגניזם פתוגני במחזור הדם או ברקמת תאים כלשהי בגוף).
הדבר מתבטא בסדרה של תגובות חיסוניות שעלולות לגרום לדלקת נרחבת, לנפיחות ולהיווצרות קרישים בזרם הדם. ודלקת קרום המוח- מחלה זיהומית שפוגעת בקרומים העוטפים את המוח ואת חוט השדרה.
אבחון GBS במעבדה
המעבדה מאבחנת את חיידק ה-GBS באמצעות סדרה של שלבים הכוללים תרבית על מצע אגר דם, גידול החיידק והזיהוי הסופי של החיידק ע"י מגוון מכשירים מעבדתיים.
הדגימה מונחת על צלחת אגר דם, שהוא מצע גידול שמספק תנאים אופטימליים לצמיחה של מגוון חיידקים. את ה GBS ניתן לראות על הפלטת דם ככדוריות קטנות בעלות גבולות ברורים, בעלות צבע חיוור ועם אזור של המוליזה (הרס של תאי דם) סביבן.
גידול זה ייחודי לעיתים קרובות לזיהוי של GBS, שכן סטרפטוקוקים אחרים לא ייצרו את אותו דפוס המוליטי, כמו סטרפטוקוקוס A אשר עשוי ליצור המוליזה מלאה (הרס מוחלט של דם) או הילה פחות ברורה.
בשלב נוסף, במידה ונדרש, ניתן לבצע זיהוי של החיידק באמצעות שיטות כמו PCR בהן מזהים את החומר הגנטי של GBS, או שיטות ביוכימיות נוספות לזיהוי התכונות המולקולריות של החיידק. כל השיטות הללו יחד מבטיחות את הזיהוי המדויק של החיידק, תוך הבדל בין סוגי סטרפטוקוקים אחרים שיכולים להימצא בסביבה.
תוצאה חיובית ושלילית עבור GBS
תוצאה חיובית בבדיקת GBS מצביעה על נוכחות החיידק במערכת של הנבדק ומחייב התייחסות של הצוות המטפל. הנשים בהריון, לדוגמה, עשויות לקבל אנטיביוטיקה כדי למנוע את העברת החיידק לתינוק. תוצאה חיובית גם עשויה להצביע על צורך במעקב אחר דלקת בדרכי השתן או זיהומים אחרים, בעיקר אם מדובר במערכת חיסונית חלשה.
תוצאה שלילית, לעומת זאת, מצביעה על כך שאין נוכחות של חיידק ה-GBS במערכת הנבדק, וזה מצביע על סיכון נמוך להידבקות או להעביר את החיידק.
צמיחה של GBS בצלחות פטריות שונות